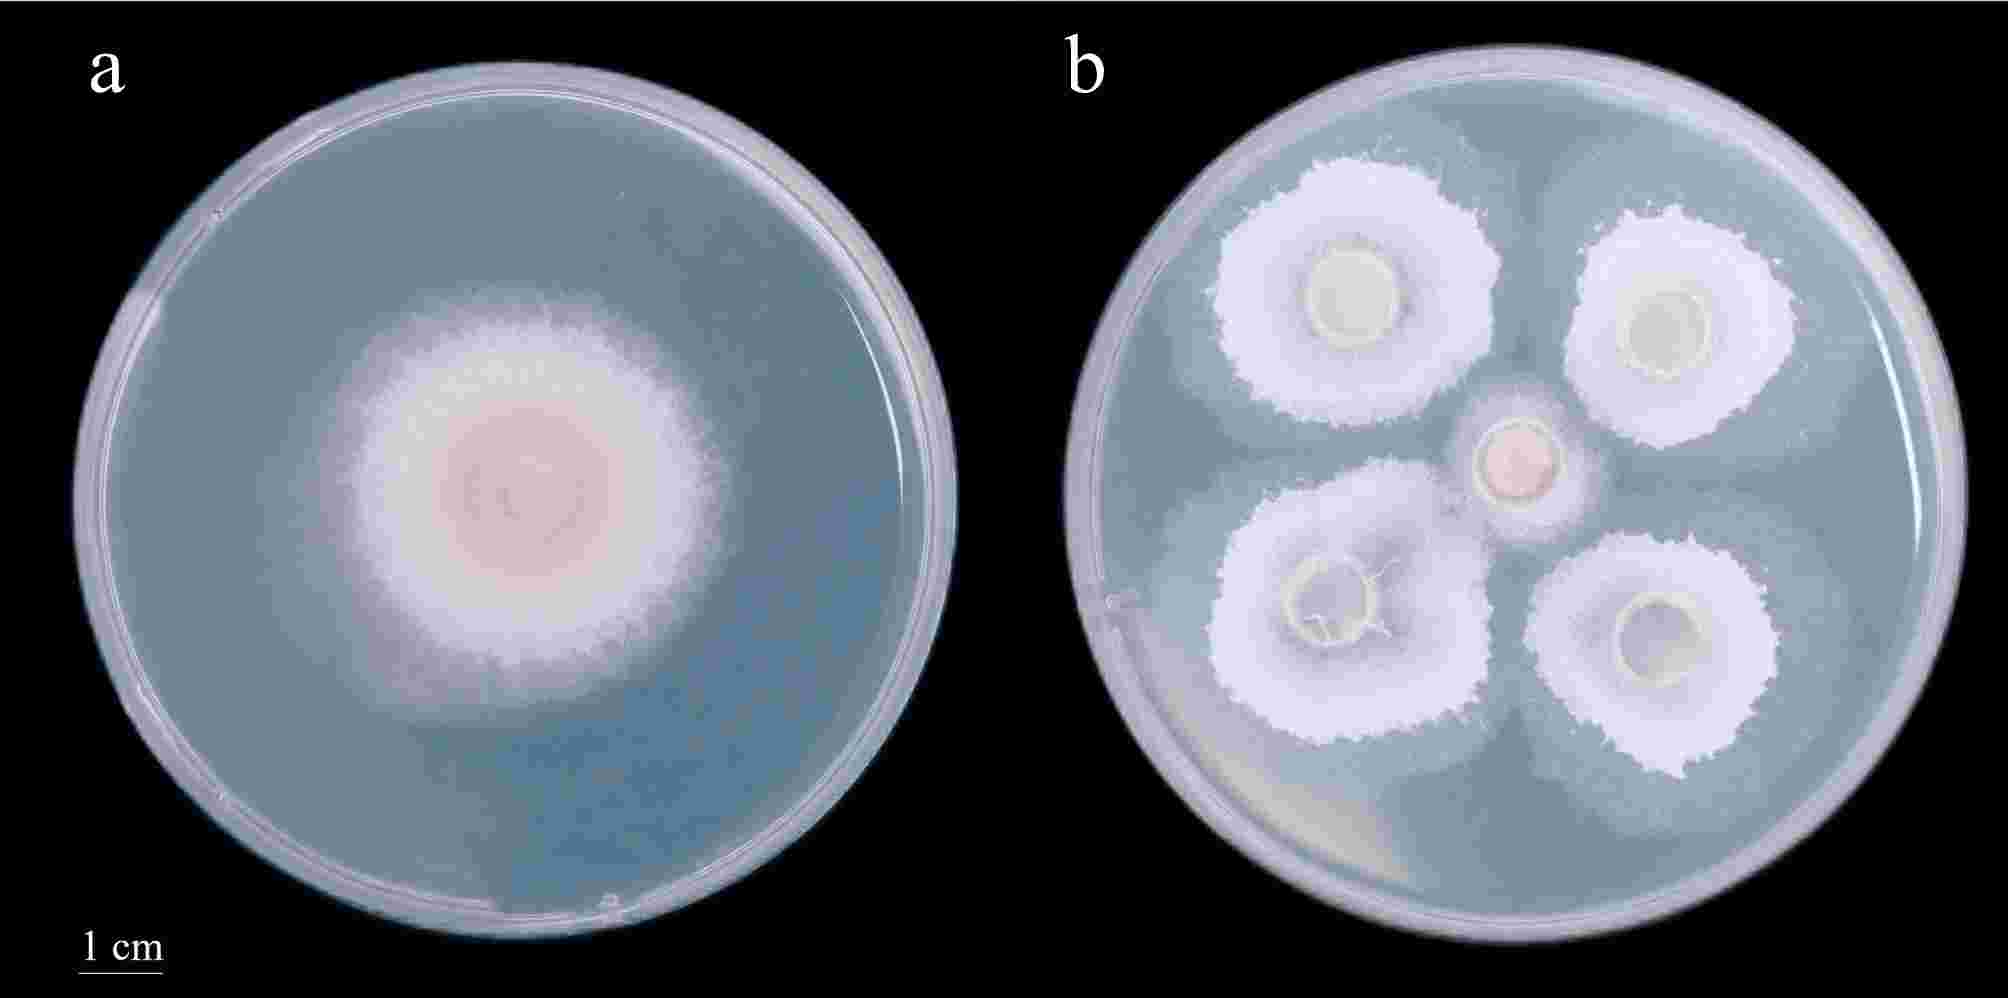
ユキ 直筆サイン入りポスター ユウ』◇ P46-125.png

マイストア
変更
お店で受け取る
(送料無料)
配送する
納期目安:
2025.10.27 8:44頃のお届け予定です。
決済方法が、クレジット、代金引換の場合に限ります。その他の決済方法の場合はこちらをご確認ください。
※土・日・祝日の注文の場合や在庫状況によって、商品のお届けにお時間をいただく場合がございます。
ユキ 直筆サイン入りポスター ユウ』◇ P46-125.pngの詳細情報
直筆サイン入りポスター ユウ』◇ P46-125.png。楕円皿 – UTSUWA HIYORI。Japanese Used Mini-Excavators HITACHI ZX55UR-5B TOKU WORLD。Hitachi ZX 270 LC。ユキ様用
ベストセラーランキングです
近くの売り場の商品
カスタマーレビュー
オススメ度 4.6点
現在、3156件のレビューが投稿されています。

![パナソニック デジタルコードレス電話機 VE-GZL40DL-K [ブラック]](https://static.mercdn.net/item/detail/orig/photos/m58200668698_1.jpg)











